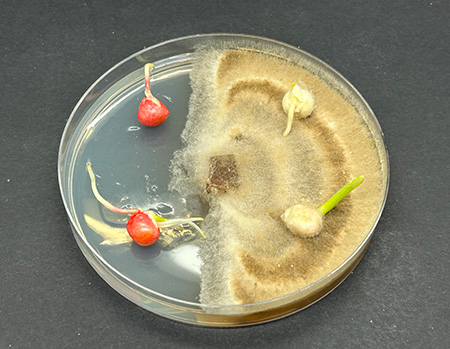

Our unmatched team of local professionals live and work in your community. They’re ready to help you select high-yielding products and provide year-round service and expertise. Have questions? Ask your local Pioneer sales representative today.
Find My Local TeamLumialza® Nematicide Seed Treatment
Lumialza® nematicide seed treatment shields against yield-robbing nematodes. Lumialza nematicide seed treatment is new to the Pioneer® brand corn seed treatment lineup. It brings new value to farmers as a biological nematicide that protects against harmful nematodes while working with beneficial organisms in the soil that improve nutrient and water uptake. Hear from Ron Sabatka on this cool new technology available for your Pioneer brand corn products.